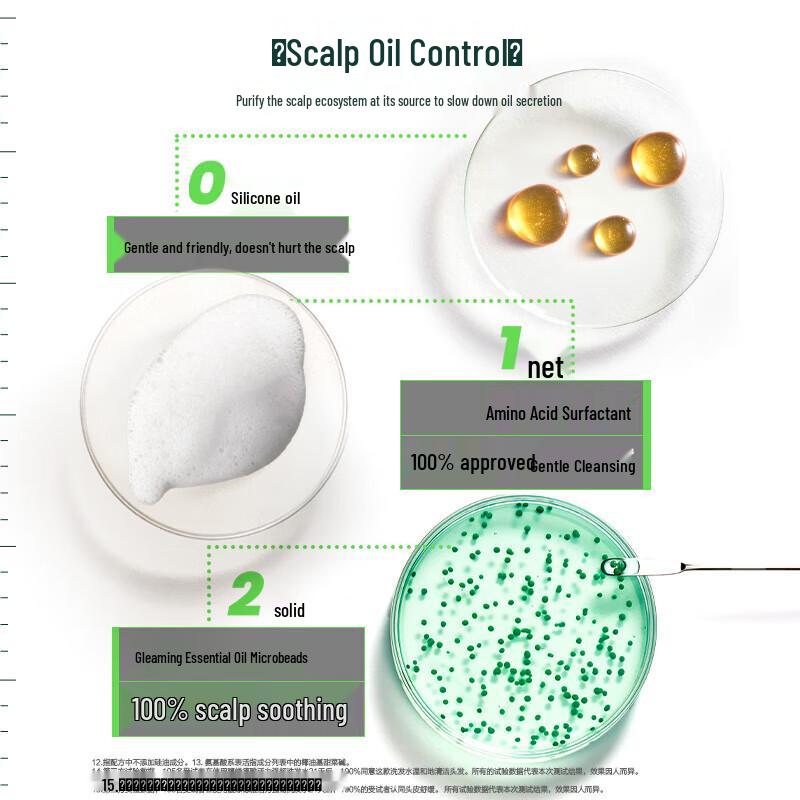
L'Oréal Men's Oil Control Cleanser & René Furterer Shampoo Set

Сайт не поддерживает ваш браузер. Пожалуйста, обновите браузер, или скачайте другой
L'Oréal Men's Oil Control Cleanser & René Furterer Shampoo Set
Цена 6 390 ₽ руб.При заказе 3+ любых товаров
Текущая цена
Цена 6 960 ₽ руб.Обычная цена

Модель
- Модный темперамент Солнечная ключичная цепочка для женщины Дофаминовое ожерелье Ювелирные аксессуары Подарок Трендовые украшения для вечеринки
- Модель 2025 года Утолщенная сельская дровяная печь для больших кастрюль и отопления
- Sesame Street Mens Cookie Monster Face Long-Sleeved T-Shirt
- Hair Loss Expert Care Shampoo Gyeongju Moon Aromatic Floral 585ml
- Lyle & Scott Mens Text Jacquard Dressing Gown
- Самоклеящаяся 3D наклейка со стразами в виде бриллиантов, акриловые кристаллы, креативные DIY поделки, драгоценные камни для украшения чехла телефона, ноутбука
- adidas SL72 OG Aurora Black W - JH6364
- Шелковое платье-трапеция с кружевом ISSA PLUS
- Наряд 80-х 90-х Костюм в стиле хип-хоп Комплект Аксессуары рэпера старой школы Браслет Цепочка со знаком доллара Украшения для Хэллоуинской вечеринки
- Черный кабель-переходник с разъемом «папа» 2,5 мм на разъем «мама» 3,5 мм для стереоаудиоразъема

Бесплатная доставка 13-23 марта
Условия возврата
Надежные платежи




Поддержка говорит по-русски
Характеристики
Срок годности
3 года
Описание
Похожие товары
L'Oréal Men's Oil Control Cleanser & René Furterer Shampoo Set — купить товар онлайн с бесплатной доставкой по всему миру!
Доступные цвета:
Качественные материалы:
Реальные фото и отзывы покупателей.
Большой размерный ряд: